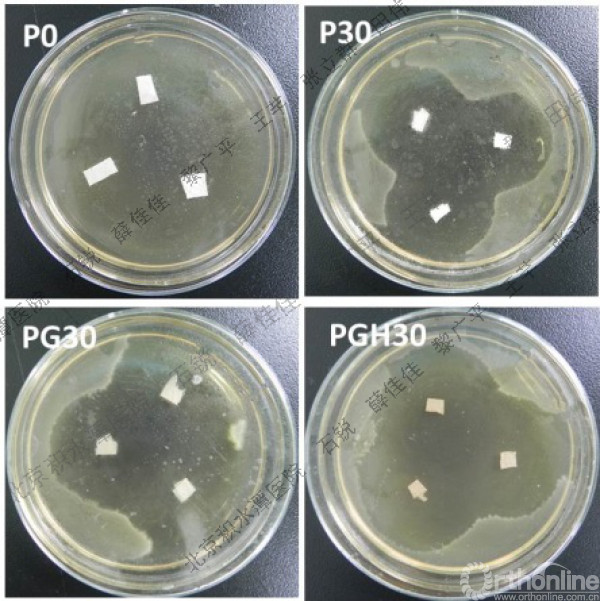

PCL基电纺纤维膜的抑菌、相容及降解性能研究
2017-05-24 作者:北京积水潭医院 石锐 薛佳佳 黎广平 王芊 张立群 田伟 我要说
[摘要]目的 探讨不同材料组成对PCL基电纺纤维膜的表面形貌、亲水性能、抑菌性能、生物相容性、屏蔽和降解性能的影响。方法 电纺丝法制备了PCL、PCL/甲硝唑、PCL/明胶/甲硝唑以及PCL/明胶/甲硝唑/醋酸纳米纤维膜,对应P0,P30,PG30及PGH30。扫描电镜(SEM)观察不同膜的表面结构。通过测量载药膜周围抑菌圈的直径来表征膜的抗菌性能。四唑盐比色法(MTT)测试测试细胞毒性。通过兔皮下埋植,伊红苏木素(H&E)染色切片法观察不同膜的组织相容性,降解性能及细胞屏蔽性能。结果 甲硝唑的引入赋予膜良好的抑菌性能。明胶引入显著提高了膜的组织相容性及降解速率。电纺液中微量醋酸(0.1% v/v聚合物溶液)能够有效提高电纺液的均一性,从而得到结构及性能稳定的纤维膜。高药物含量及微量醋酸的加入对于膜的细胞及组织相容性均无明显副作用。P0及P30在24周内均能够维持对成纤维细胞的屏蔽作用,PGH30能够维持8周,而PG30的细胞屏蔽期小于8周。结论 不同组分对纳米纤维膜的结构和性能具有不同影响。本研究将为设计广泛应用于骨科疾病治疗的膜材料奠定基础。
[关键词]聚己内酯;甲硝唑;明胶;电纺
对于术后防粘连膜及引导组织/骨再生膜基体材料而言,具备良好的力学性能,细胞屏蔽性能,抑菌性能及生物相容性具有十分重要的临床意义。由于电纺纤维膜具有类细胞外基质的结构特点(纤维直径范围50~500nm),其独特的高比表面积特点还赋予其良好的细胞相容性、药物加载及可控释放能性[1]。此外,电纺纳米纤维膜的平均孔径约为4~6µm。而真核细胞直径范围为10~100µm,因此电纺纤维膜的结构特点使其具有细胞屏蔽的功能。综上,电纺纤维膜非常适合用于制备用于隔离屏蔽膜,如术后防粘连膜及引导组织/骨再生膜。
较其它常见可降解高分子材料,如胶原、聚乳酸及聚乙醇酸等,PCL具有无免疫源性、降解过程不产生酸堆积、生物相容性好、柔韧性强、力学强度高、共混相容性好等诸多优点,这些优点使得PCL在生物医用领域有着广泛的应用[2,3]。因此,本研究拟采用PCL作为基体材料制备纤维膜。但是由于PCL在体内的吸收时间约为2~3年[4,5],这对于可吸收隔离膜来说过于缓慢。此外,PCL属于疏水性聚合物,不利于细胞粘附。因此,为了改善PCL的降解性能及生物相容性,需要将PCL与其它降解速率快且亲水性能好的聚合物共混或共聚。
明胶是胶原的水解产物,不但降解吸收速率快,无免疫原性,而且明胶分子上保留了大量有助于细胞粘附、分化及增殖的氨基酸序列[6],因此,本研究选用明胶与PCL共混制备复合纳米纤维膜从而提高膜的相容性及降解速率。
当天然与合成聚合物溶液共混时,尤其当天然聚合物组分浓度达到一定临界值时,共混电纺液非常容易发生相分离,这将直接导致纳米纤维膜结构分布不均及性能不稳定。因此,需要增加纺丝液中不同组分间的相容性从而提高膜的结构及性能均一性。研究表明,在纺丝液中加入微量无机酸可促进溶液中天然及合成聚合物之间的相容性,有效抑制相分离的发生[7]。然而,微量酸的引入是否会对膜的生物相容性及降解性能产生相应影响,目前还没有相关的研究。
由细菌引发的感染被认为是引发植入体内生物材料失效的主要原因。据报道约有22%的翻修手术是为了治疗由术后感染引发的骨科植入术失败[8]。传统的全身给药法需要持续口服高浓度药物,不可避免会引发系统毒性并增加肝肾负担。为了使药物到达深处感染组织,并维持有效浓度并规避系统性副作用,需要通过局部可控药物释放来解决[9,10]。较深组织部位的感染往往是由于厌氧菌引起的,甲硝唑(MNA)治疗由厌氧菌引起的感染已有45年历史,但以PCL为基体的材料加载甲硝唑的纳米纤维膜的研究还很少。尤其是高药物加载量对于膜的生物相容性及降解性的研究还没有相关报道。
本研究以PCL作为基体材料,用电纺丝法制备了PCL、PCL/MNA、PCL/明胶/MNA以及PCL/明胶/MNA/醋酸(HAC)纳米纤维膜。重点考察了不同材料组成对膜的表面形貌、亲水性能、抑菌性能、细胞屏蔽性、生物相容性和降解性能的影响。本研究结果对于理解不同组分对纳米纤维膜相关性能的影响具有重要作用,对设计具有综合性能优良的术后防粘连膜及引导组织/骨再生膜具有十分重要的意义。
1 材料和方法
1.1 材料制备
电纺液组成及制备:将医用级PCL(Sigma-Aldrich)溶解于二氯甲烷(DCM)与氮,氮二甲基甲酰胺(DMF)混合溶液中DCM:DMF(60:40v/v),配制成浓度为10wt%的溶液,室温下搅拌24小时,得到P0的电纺液;完成上述步骤后,再将占PCL质量30%的MNA加入PCL溶液中,继续搅拌12小时,获得P30的电纺液;室温搅拌12小时分别制备浓度为6wt%的PCL/六氟异丙醇(HFIP)溶剂以及明胶/HFIP溶剂。将两种溶剂按照50:50(w/w)共混。再将占PCL和明胶总质量30wt%的MNA加入混合好的溶液中,继续搅拌12小时获得PG30电纺液;在上述PCL/明胶/MNA溶液中,继续加入占整个溶液体积0.1%v/v的HAC溶液,继续搅拌12小时,得到PGH30电纺液。
电纺工艺条件:注射器容积20ml,针头直径0.4mm,注射速度为1ml/h,圆筒收集器转速为300rpm,注射针头距离接收器距离为20cm,纺丝电压范围为8~12KV,所有电纺过程在室温下,40%的相对湿度环境中进行。
1.2 表面形貌
扫描电子显微镜(SEM)(S4700,Hitachi Co.,Tokyo,Japan)用于膜的表面形态观察,扫描电压20KV。膜表面经过喷金处理。
1.3 静态水接触角
膜的静态水接触角(Contact angle,CA)通过SL200A(Solon Technology Science Co.,Ltd.,上海,中国)测量。
1.4 抑菌性能
将边长为1.0cm×1.0cm的纳米纤维膜样品放入含具核梭杆菌的琼脂培养皿中(每个培养皿中三个样品)。培养皿置于37℃厌氧环境中,分别于1、4、7、14、21及30天取出观察并测量抑菌圈直径。
1.5 体外细胞相容性测试
材料浸提液的制备:将大小20mm×30mm的样品,用75%(v/v)酒精清洗后按照3cm2/ml浸泡在37℃的DMEM中24小时,再通过过滤器(孔径大小0.22μm)过滤获得测试样品的浸提液。
MTT法测细胞毒性:用96板培养L929小鼠成纤维细胞,接种细胞浓度为5×104/ml,24小时后吸去培养液,加入等量材料浸提液,阴性对照用含有10%胎牛血清(FBS)的DMEM培养液,分别于24、48及72小时,经5mg/mlMTT和酸化异丙醇处理后,用酶联仪在630nm波长测其吸光度值,取平均值。计算细胞相对增殖率(relative growth rate,RGR)和细胞毒性分级详见表1。其中RGR=(试样OD值-空白OD值)/(阴性OH值-空白OD值)。

表1 RGR和细胞毒性分级
1.6 体内组织相容性及降解性能测试
将不同样品裁成边长10mm的正方形,CO60消毒。取新西兰大耳白兔25只,体重约2.5kg左右,雌雄不限,随机分为5组,每组5只。采用兔脊柱旁皮下埋植实验,将样品分别植入兔脊柱两侧皮下,在距脊柱中线约25mm处切8mm长的切口,用钝器解剖法在皮肤切口部位制备一个皮下囊,囊底部距缺口距离为10mm,将样片植入囊中后完全展开,缝合伤口。脊柱同侧每个样品之间的距离约15mm。在植入后1、3、8、12、24周后将膜与周边组织一并取出,立刻在4%的福尔马林溶液中固定1周。分别行H&E染色组织切片观察和电镜观察。固定样品脱水后石蜡包埋,制成5μm切片,然后通过H&E染色制片后,在显微镜下观察。
1.7 统计学处理
学生t-检验用于验证数据间的差异性,置信区间为95%,每个数据点表示为平均值±标准偏差。
2 结果
2.1 表面形貌
P0、P30、PG30和PGH30的表面形貌图片在图1中显示。如图1所示,载药纳米纤维膜的表面都有少量MNA颗粒的聚集。纯PCL纳米纤维呈无规排布,纤维表面光滑,直径分布均匀。由于MNA的分子具有极性,因此加入MNA后(P30)纺丝液的电导率会增加,从而导致纤维直径减小。
对PG30,在电纺起始时电纺液呈透明均匀状,过3~4小时,电纺液开始变得浑浊并出现相分离现象,8~12小时后,电纺液出现了明显的分层现象。电纺液的相分离现象直接导致了纤维直径分布不均。根据纤维直径分布,较粗纤维直径约为(1.51±0.3)μm,而较细纤维直径约为(0.30±0.1)μm。
对PGH30,我们采用将微量的醋酸加入PCL与明胶的混合电纺液中,混合均匀后在室温下放置24小时后电纺液仍然能够保持透明均匀的状态,因此得到的纳米纤维也非常平滑且直径分布均匀。

图1 不同组分PCL基纤维膜的SEM图片
2.2 表面亲水性能
图2为水滴落在膜表面5秒后的形态照片,静态水接触角(Contact angle,CA)值见表2。随MNA及明胶的加入,CA变小。由此可见MNA及明胶的引入均能够显著提高膜的亲水性能。虽然PG30与PGH30中明胶含量基本相同,但PGH的水接触角却明显大于PG30,亲水性能略有下降。

图2 水滴落至不同组分PCL基纤维膜表面5秒后的形态照片

表2 不同组分PCL基纤维膜表面的静态水接触角CA(°)
2.3 抑菌性能
通过具核梭杆菌的生长状况可以直观观察不同MNA含量的纳米纤维膜的抑菌效果,图3为培养30天后不同膜周围的抑菌圈照片。不同样品在不同时间段抑菌圈的直径大小见图4。由图3可见30天后不含药物的P0所在琼脂板完全被细菌所覆盖,但其他载药膜30天后仍保持着较好的抑菌活性。含明胶的PG30及PGH30样品周围的抑菌圈直径大于不含明胶的P30样品周围的抑菌圈直径。对于P30来说,抑菌圈直径随时间延长变小,但PG30和PGH30的抑菌圈直径在30天内的变化不大。
图3 37℃无氧条件下孵化30天后不同组分PCL基纤维膜表面周围的抑菌圈形貌

图4 不同组分PCL基纤维膜不同时间段抑菌圈直径
2.4 细胞毒性测试

图5 体外细胞毒性实验结果:a:L929细胞在不同PCL基纤维膜浸提液中的RGR/%;b:72小时后L929细胞在不同PCL基纤维膜浸提液中的形态照片(100×)
如图5所示,L929细胞在不同纤维膜样品浸提液中培养24小时后,4个样品的RGR值与阴性对照组磷酸三钙TCP相比,无统计学差异。72小时后含明胶的样品(PG30,PGH30)中细胞的RGR值要明显高于不含明胶的样品(P0及P30)。不含明胶样品中细胞的RGR值在72小时内呈下降趋势,但在含明胶的样品中细胞的RGR值却呈现相对上升的趋势。72小时后PG30浸提液中细胞的相对增值率明显高于其它样品,甚至高于对照组,证明明胶的引入确实能够提高材料的细胞相容性。
由图5b可见72小时后,细胞形态呈现轴状、三角形及四边形态,说明细胞具有良好的生长态势。尽管MNA的含量很高(占聚合物质量的30%),但高浓度MNA的释放对细胞并没有造成不良影响。三个时间点(24、48、72小时)都呈现L929细胞在PGH30浸提液中的RGR值都要低于PG30,这说明微量醋酸的引入对材料的细胞毒性确实产生了一定影响,但72小时后PGH30中的RGR值达到93%,仍然高于P0及P30中的RGR值,说明醋酸对细胞毒性负面影响并不大,PGH30仍然具有良好的生物相容性。
2.5 体内组织相容、细胞屏蔽及降解性能
长期皮下埋植实验用来考察药物以及降解产物对组织相容性的影响。实验过程中,所有兔子生理状况良好,未发生任何与手术伤口相关的并发症。任意观察时间点无明显的急性及慢性炎症反应,组织坏死及其它不良组织反应。H&E染色及组织切片观察结果如图6所示。

图6 皮下埋植不同时间段不同PCL基纤维膜及周围组织的H&E染色照片
术后一周,4种膜材料周围均未发现中性粒细胞,证明均无明显急性炎症反应发生。4种膜周围都可见少量的单核细胞、血管及肉芽组织,但载药膜周围的细胞浸润数目要小于非载药膜,证明载药膜的宿主反应较轻。1周后P0的结构完好,但已经有少量组织细胞迁移到P30表面及以下部位,说明P30已经开始发生了表面降解。P30周围的血管及肉芽组织也多于P0,说明P30的降解较P0快。对于含明胶的膜(PG30及PGH30)来说,1周后膜都呈现出透明状,降解不仅发生在膜的表面,而且还发生在膜的内部,且已经有一些组织细胞进入了PG30及PGH30的内部,但PGH30内部的细胞数量明显少于PG30,证明PGH30的降解速率确实低于PG30,因此PGH30的细胞屏蔽性能优于PG30.
术后3周后各膜的降解程度均较术后一周更深。不同膜周围的单核细胞数目增多,肉芽组织,新生微小薄壁血管以及纤维囊也进一步增长,纤维组织进一步向材料内部移行,并伴随出现少量巨噬细胞开始吞噬材料。P0周围的纤维囊厚度略大于P30,而纤维囊厚度越小,证明组织相容性越好。3周后P0和P30的降解程度类似,但对于PG30来说,膜内部出现明显的空洞及分层现象,证明膜的降解现象严重。而PGH30内部未出现大量空洞及分层,证明降解没有PG30快,进一步证明了微量醋酸的引入有助于延长降解速率。此外,纤维母细胞及巨噬细胞均未穿透膜,PG30与PGH30在3周内都保持着良好的细胞屏蔽性能。
术后8周,各膜都被大量的纤维母细胞、单核细胞、多核巨噬细胞、新生血管组织以及肉芽组织所包裹。P0内部出现少量空洞,但还没有细胞侵入P0内部。P30的膜厚度以及纵切面形貌与P0类似,内部也出现少量空洞。8周时仍然没有细胞透过P0和P30。相对于P30来说,P0周围聚集了更多巨噬细胞,证明MNA的引入具有抑制巨噬细胞聚集的作用。对于PG30,大量的材料已经被纤维组织所替代。大量组织细胞、单核细胞、多核巨噬细胞以及血管组织长入了膜的内部,膜和组织之间已经有部分整合,此时PG30已经完全丧失了细胞屏蔽性能。相对于PG30来说,尽管PGH30内部出现了大量空洞,但细胞并没有穿透膜,再次证明了PGH30的降解较PG30慢,细胞屏蔽性能更好。
术后12周,各膜的厚度都有所下降。P0及P30周围的血管组织变得更加丰富,纤维囊厚度也都有所增加,大量巨噬细胞聚集在膜表面,但仍然未见细胞穿透膜。对于PG30,只能看到材料降解后的碎片。PGH30也降解成碎片状,丧失了细胞屏蔽性能,但碎片要大于PG30。
术后24周,P0及P30明显变薄,但完整性及细胞屏蔽性能保持良好。PG30和PGH30的纳米纤维的结构完全消失,材料近乎被细胞完全吞噬。
3 讨论
本文研究了4种以PCL为基体的纳米纤维膜的结构及相关性能。不同组分造成材料的宏观及微观结构发生变化,从而引起理化及生物学性能的改变。
一般来说,溶液导电性的增加会导致纺丝喷头聚集大量电荷,因此在电场作用下喷头处会产生更强的拉伸力,从而使得射流路径变短,对电纺液的拉伸力变强因此纤维直径减小。PCL属于非极性聚合物,当溶解于有机溶剂时,在溶液中不产生离子。加入MNA后,溶液极性增加,导电率增加。因此,P30的平均纤维直径要小于P0。纤维直径变小有助于纤维更紧密堆积,因此,P30的平均孔径较P0小。对于PG30来说,明胶及MNA都加入PCL的电纺液中,而明胶属于高分子电解质,溶解后会产生大量电荷[11]。因此相对P30,PG30的纺丝液的导电性更强,纺出的纤维平均直径也应该更细,但实际PG30的纤维直径分布非常不均匀,这主要是由于电纺液的相分离造成的。PCL/明胶溶液在混合初期呈均匀且透明的状态,但在纺丝过程中逐渐变得浑浊并发生相分离。当PCL与明胶的质量比为1:1时,混合后3~4小时开始出现相分离现象,8~12小时后电纺液出现明显的分层现象。当电纺速率为1ml/h时,纺成厚度为250μm的膜时大概需要20小时,因此电纺液在纺丝过程中逐渐发生了相分离,PG30膜的组成及结构在电纺过程中逐渐发生着变化,从而导致纤维直径分布不均。结构的不均匀将会导致性能的不稳定,这在大规模工业化生产过程中将会造成产品质量的不稳定。
为了解决这个问题,我们通过在电纺液中加入微量醋酸来改善电纺液中PCL与明胶之间的相容性,从而提高纤维膜结构的均匀性。当在明胶溶液中加入PCL溶液时会导致共混液pH值发生变化,从而接近明胶的等电点[12],使得明胶发生沉降所导致相分离。明胶是一种典型的多聚两性电解质,同时包含氨基及羧基,因此明胶分子对其周围环境刺激具有响应性。六氟异丙酮(HFIP)溶剂具有较强的酸性,因此明胶分子在HFIP溶剂中会暴露质子基团并屏蔽非极性基团。然而当明胶/HFIP和PCL/HFIP溶液共混时,明胶分子与其周围疏水性的PCL分子接触,明胶分子会发生反转,将其疏水基团暴露并与PCL分子相互作用,导致溶液的pH值及zeta电势更接近明胶的等电点,因此明胶分子就会变形并形成微小颗粒分散在溶液中,当明胶浓度较大时,这些小颗粒会互相接触并粘附在一起,当聚集形成的颗粒足够大时,就会沉降在溶液的底部,发生相分离。在体系中引入微量酸后,明胶表面的氨基会发生质子化从而带正点,因此明胶分子就会发生相互排斥,并且展开的明胶分子链可以与PCL分子相互作用,形成均匀透明的溶液。利用这个原理可以实现分子水平的均一性,从而得到结构均匀的共混纤维膜,这对于获得性能稳定的产品具有十分重要的意义。
材料的亲水性对细胞粘附及增殖有极大影响[13]。由于MNA上带有极性的羟基及咪唑功能基团,明胶分子上带有大量的氨基及羧基基团,所以将MNA和明胶与PCL共混均能提高材料亲水性。PG30与PGH30之间的亲水性差异主要是材料的均一性差异造成的。明胶在电纺过程中沉积在PG30电纺液的底部,因此在电纺最后阶段形成的表面中明胶含量较高。由于明胶亲水性非常强,导致PG30的表面亲水性能高于PGH30的原因。
抑菌试验用来检测在相同载药量下,不同材料组成对于抑菌性能的影响。由于明胶降解速率非常快,因此共混材料中明胶相所含药物会迅速扩散至培养皿中,因此含明胶的样品PG30与PGH30的初始抑菌活力要高于P30。此外由于明胶分子上的亲水基团要多于PCL分子上的亲水基团,因此,更多的药物分子存在于明胶相中。因此PG30和PGH30释放的药物总量要多于P30,抑菌效果更明显。
皮下埋植实验用来评价局部高浓度的MNA以和微量HAC的引入对局部组织造成的影响。此外,不同组分膜的降解性能以及细胞屏蔽性能也能通过组织切片观察得到直接结果。
膜的降解速率直接影响膜的细胞屏蔽性能及再生空间维持性能。由于MNA的加入能够提高膜的亲水性,因此也会加速膜的降解。此外由于MNA的引入能够抑制组织细胞及单核细胞的聚集,因此MNA的引入在一定程度上能够降低材料植入体内后引起的宿主反应。对于含明胶的样品,随着明胶的快速溶解,大量的纤维母细胞、单核细胞、多核巨噬细胞以及血管就很容易随着降解后的孔长入膜的内部,从而导致PG30与PGH30的快速降解。与PG30相比,PGH30对成纤维细胞的隔离屏蔽性能保持时间更长,这是由于PGH30中PCL的分布较为均匀,又由于PCL的降解吸收速率较慢,因此纤维膜骨架结构能够维持的时间较PG30长,因此微量醋酸的加入还有助于维持纳米纤维膜的细胞屏蔽性能及延长降解时间。
无论对于GTR/GBR膜还是术后防粘连膜,都需要具备良好的细胞屏蔽性能,尤其作为GTR/GBR膜,希望在3~6个月内维持膜的阻隔性能从而保护硬组织的再生。本研究结果显示P0及P30能够在体内植入6个月后维持其结构完整性。明胶的引入显著提高膜的降解速率。本研究结果表明当PCL和明胶比例为50:50(W/W)时,该膜只能在体内维持8周的细胞隔离屏蔽功能,因此,当作为GTR/GBR膜时,最好能够适当减少明胶所占的比例。
综上所述,我们制备了4种不同组分的以PCL为基体的纳米纤维膜材料。这些PCL基纳米纤维膜可以潜在应用于对降解速率有不同需求的部位。此外,PCL基载药膜可以广泛适用于需要局部药物释放的部位,如伤口敷料、术后防粘连以及引导组织/骨再生的部位。
参考文献
[1]Sill TJ,Von RHA. Electrospinning: Applications in drug delivery and tissue engineering[J]. Biomaterials,2008,29(13): 1989-2006
[2]Woodruff MA, Hutmacher DW. The return of a forgotten polymer-polycaprolactone in the 21st century[J], Prog. Polym. Sci, 2010, 35(10):1217-1256.
[3]Nair LS, Laurencin CT. Biodegradable polymers as biomaterials[J], Prog. Polym. Sci,2007, 32(8-9):762-798.
[4]Stamatialis DF, Papenburg BJ, Gironés M, et al. Medical applications of membranes: drug delivery, artificial organs and tissue engineering[J]. Journal of Membrane Science, 2008,308(1-2):1-34.
[5]Yang F, Both SK, Yang X, et al. Development of an electrospun nano-apatite/PCL composite membrane for GTR/GBR application[J]. Acta Biomater. 2009,5(9):3295-3304.
[6]LeeJ,TaeG,KimYH,et al.The effect of gelatin incorporation into electrospun poly(L-lactide-co-epsilon- caprolactone)fibers on mechanical properties and cytocompatibility[J]. Biomaterials, 2008, 29(13):1872 -1879.
[7]Feng B, Tu HB, Yuan HH, et al. Acetic-Acid-Mediated Miscibility toward Electrospinning Homogeneous Composite Nano fibers of GT/PCL[J]. Biomacromolecules, 2012,13(12):3917 -3925.
[8]Coello R, Charlett A, Wilson J, et al. Adverse impact of surgical site infections in English hospitals[J]. Hosp Infect, 2005, 62(3):93-103.
[9]Feng K, Sun H, Bradley MA, et al. Novel antibacterial nanofibrous PLLA scaffolds[J].Controlled Release, 2010, 146(3): 363-369.
[10]Vacanti NM, Cheng H, Hill PS, et al. Localized delivery of dexamethasone from electrospun fibers reduces the foreign body response[J].Biomacromolecules, 2012,13(10):3031-3038.
[11]Y. Zhang, H. Ouyang, C.T. Lim, et al. Electrospinning of gelatin fibers and gelatin/PCL composite fibrous scaffolds[J]. Biomed Mater Res Part B: Appl. Biomater, 2005, 72B(1):156-165.
[12]Mohanty B, Bohidar HB. Systematic of alcohol-induced simple coacervation in aqueous gelatin solutions[J]. Biomacromolecules, 2003, 4(4):1080-1086.
[13]L. Wu, H. Li, S. Li, et al. Composite fibrous membranes of PLGA and chitosan prepared by coelectrospinning and coaxial electrospinning[J]. Biomed Mater Res, 2010,92A(2):563-574.



京公网安备11010502051256号